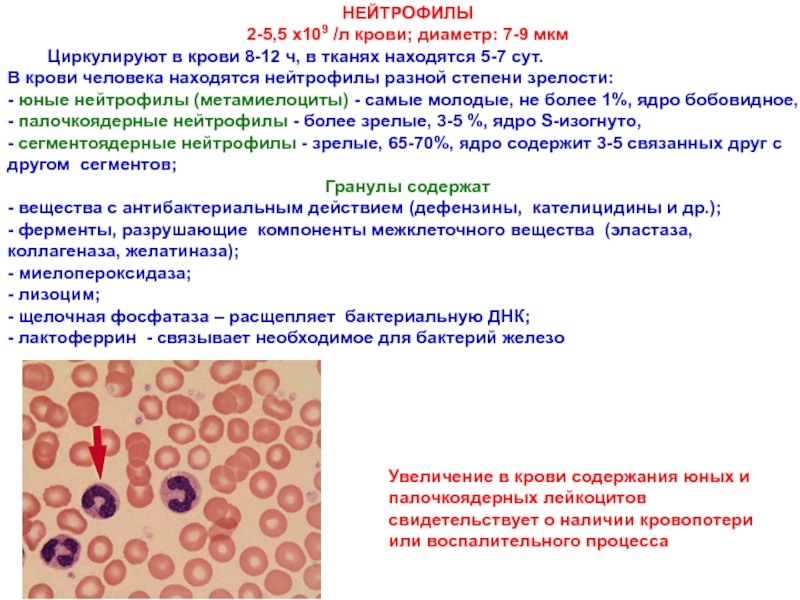

внутреннюю среду организма;
источник развития – мезенхима;
хорошо выражено межклеточное вещество;
разнообразием клеточного
состава;аполярность клеток;
хорошо кровоснабжаются
Функции
- обеспечение внутреннего обмена, постоянства внутренней среды - гомеостаза;
- защитная;
- опорно-механическая.